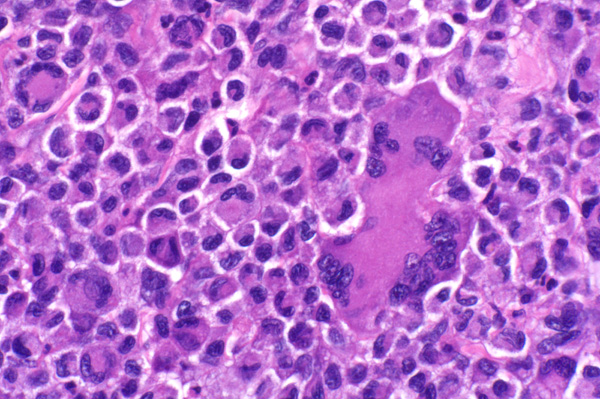

| 40x | Hematoxylin and Eosin | ||||
| Close Window | Macro View | Back | ||
|
Neoplastic cells have eccentric nuclei and moderate amounts of granular, eosinophilic cytoplasm. Multinucleated giant cells are common.
|
||||
|
|
||||
| Return | ||||
|
Neoplastic cells have eccentric nuclei and moderate amounts of granular, eosinophilic cytoplasm. Multinucleated giant cells are common.
|
||||